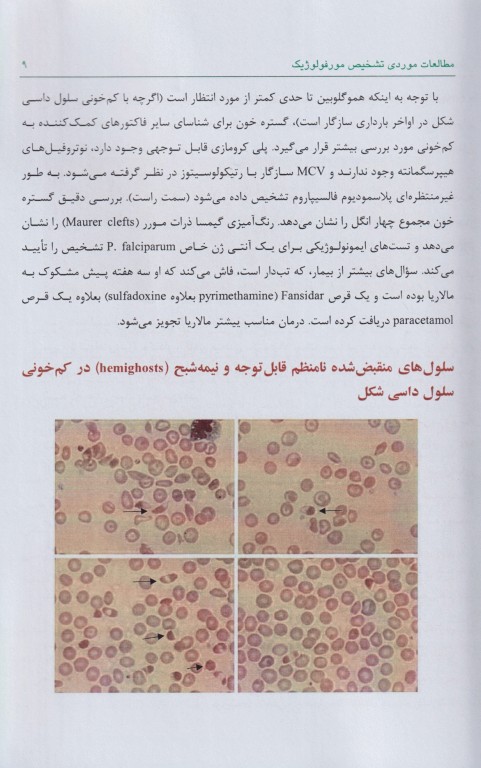
خونشناسی مطالعات موردی تشخیص مورفولوژیک

کتاب خونشناسی مطالعات موردی تشخیص مورفولوژیک بهمراه سوالات چند گزینهای اثر باربارا جی.بین ترجمه محمدرضا کاظمی توسط انتشارات آناطب به چاپ رسیده است. این کتاب بر اساس مجموعهای از به روزرسانیهای مورفولوژی در حال انجام که در ژورنال هماتولوژی آمریکا از سال 2008 منتشر شده است و در صورت ضرورت مطالعات موردی به روزرسانی شده و یک بخش تست خودآزمایی به آن اضافه شده تهیه شده است.
هدف این کتاب، رساندن اهمیت مورفولوژی هماتولوژیک به خوانندگان است. در انتخاب موارد مطالعاتی گنجانده شده، اولویت به مواردی داده شده است که بررسی میکروسکوپی برای تشخیص حیاتی است و مواردی که یک پیام کلی وجود دارند.